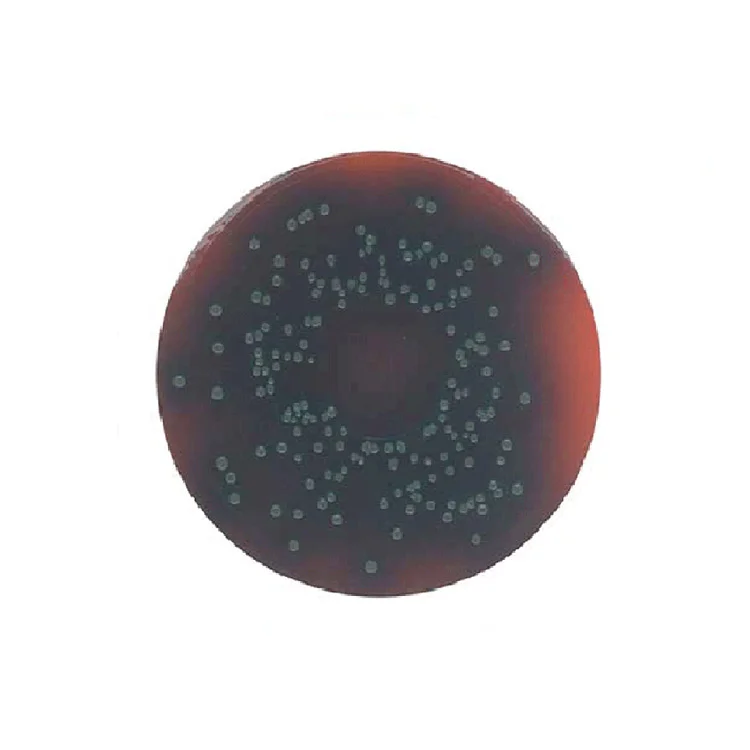

محیط کشت پالکام آگار
تماس بگیرید
- PALCAM Listeria Selective Agar
با توجه به نوسانات قیمت محصولات لطفا قبل از ثبت سفارش با کارشناسان آریاطب تماس بگیرید
تماس بگیرید
قیمت ویژه همکاران
اکانت شما ویژه همکاران نمی باشد
محیط کشت پالکام آگار PALCAM Agar
درست مانند یک ماده رشد انتخابی که به صورت افتراقی کشت می شود و جداسازی و تمایز گونه ی لیستریا از مواد غذایی را انجام می دهد و گرم مثبت هستند که به صورت میله ای حرکتی بسیار کوتاه و ناهمگن قابل استفاده می باشند تحرک آن ها در بهترین دما فقط دمای ۲۵ درجه امکان پذیر می باشد.
پالکام لیستریا سلکتیو آگار
همچنین نیاز به سرکوب نمودن سیستم ایمنی بدن در برابر تولید بیماری هایی که بیشتر نوزادان در معرض خطر هستند را سرکوب می کند البته به عنوان یک ارگانیسم بیماری زا نیز شناخته شده و کار اصلی آن ها جداسازی مواد غذایی و مواد دفعی بیولوژیکی حتی نمونه های زیست محیطی که به شدت آلوده شده اند به کار می رود.
پالکام آگار
پالکام لیستریا
نظر خود را ارسال کنید
آدرس ایمیل شما منتشر نخواهد شد. فیلدهای الزامی علامت گذاری شده اند *
قیمت ویژه همکاران
اکانت شما ویژه همکاران نمی باشد
اطلاع از موجودی